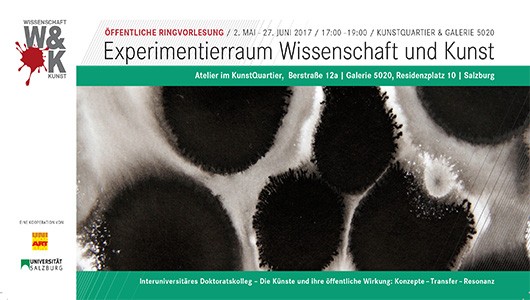
�Brigitte Kovacs

Lecture by Katharina Anzengruber: KLANGKÖRPER - KÖPERKLANG within the course of the public lecture series "Experimentierraum Wissenschaft und Kunst", conceptualized by the doctoral candidates of the Doktoratskollegs, "The Arts and their Public Impact: Concepts - Transfer- Resonance". Date: 30 May. Time: 17:00. Location: at the Atelier in the KunstQuartier, Bergstraße 12a, 5020 Salzburg. In cooperation with the UNI 55-PLUS. Wie können experimentelle Kunstformen in der Schule vermittelt werden? Worin liegen die Unterschiede zum Experimentieren im naturwissenschaftlichen Unterricht? Was 'lernen' die Schülerinnen und Schüler beim Experimentieren? Diese und andere Fragen werden am Beispiel eines interdisziplinären Schulprojektes, bei dem das Experimentieren mit Klängen aus künstlerischer und naturwissenschaftlicher Perspektive im Zentrum steht, zum Thema. Dem Experiment(ieren) kommt auch im Rahmen der Vorlesung selbst Bedeutung zu! Programm Wissenschaft und Kunst haben mehr gemeinsam, als es auf den ersten Blick den Anschein hat.
TO READ THIS ARTICLE, CREATE YOUR ACCOUNT
And extend your reading, free of charge and with no commitment.
Your Benefits
- Access to all content
- Receive newsmails for news and jobs
- Post ads